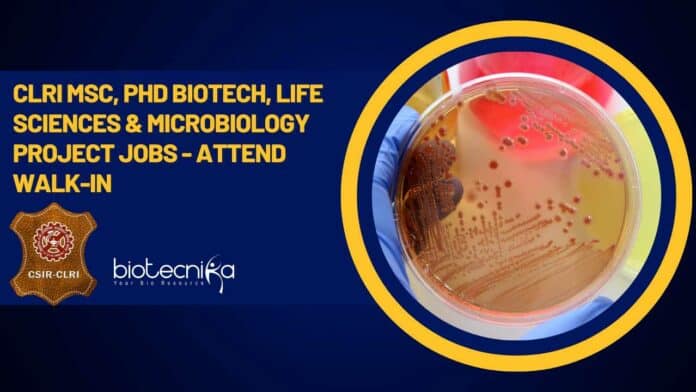

CLRI Project Openings 2023 For MSc, PhD Life Sciences – Attend Walk-In
CLRI Project Openings 2023 For MSc, PhD Life Sciences – Attend Walk-In. CLRI Careers 2023. CSIR-CLRI Vacancies. Interested and eligible applicants can check out all of the details on the same below
Hey there, make sure you check out all of the possible interview questions for the various roles at CSIR -Central Leather Research Institute (CLRI) below.
This job expires in
CSIR – CENTRAL LEATHER RESEARCH INSTITUTE
Council of Scientific & Industrial Research
Adyar, Chennai – 600 020, Tamil Nadu, India
No.23(368)/2023-EI
Notification No.04/2023
Walk-in-Interview
Engagement to the positions of Project Associate-I / Junior Research Fellow / Senior Project Associate on temporary basis to work in CSIR-CLRI
CSIR -Central Leather Research Institute (CLRI), Chennai is a National Laboratory under the aegis of the Council of Scientific & Industrial Research (CSIR). It is one of the World’s premier Institute engaged in Research & Development in the area of Leather Science & Technology and is associated with several National & International Program
CSIR-CLRI desires to engage talented candidates as Project Associate-I / Junior Research Fellow/ Senior Project Associate on a temporary basis in various projects tenable at CLRI as per qualification, age etc., detailed in the table below:
Post I
Name of the Post – Project Associate-I
No. of Posts – 01
Tenure – 01 year
Upper Age Limit – 35 years
Monthly Emoluments – Rs.25,000/- plus HRA
Essential – M.Sc Biotechnology from a recognized University/ Institute.
Desirable – Experience in bulk production, Factory plant erection and commissioning, DPR layout preparation in AutoCAD.
Post II
Name of the Post – Project Associate-I
No. of Posts – 01
Tenure – 01 year
Upper Age Limit – 35 years
Monthly Emoluments – Rs.25,000/- plus HRA.
Essential – M.Sc Biotechnology/ Microbiology from a recognized University/ Institute.
Desirable – Candidates having one-year experience in research or teaching & training will be given preference.
Post III
Name of the Post – Senior Project Associate
No. of Posts – 01
Tenure – 01 year
Upper Age Limit – 40 years
Monthly Emoluments – Rs.42,000/- plus HRA
Essential – PhD in Life Sciences
Desirable – Experience and publications in Biomaterials.
* Tenure mentioned above may be extendable. In any case, it is a co-terminus with the project or till such time this requirement exists whichever is earlier.
$ Age relaxation as per Government of India / funding agency norms: 28 years which is relaxable upto 5 years in case of candidates belonging to Scheduled Castes/Scheduled Tribes, women and physically handicapped applicants and 3 years in case of OBC (Non-Creamy Layer) candidates
Note: As per CSIR letter No. 5-1(342)/2015-PD dated 12.01.2023, engagement of Project Staff shall be co-terminus with the term of the Project subject to the condition that the total period of the engagement of a Project Staff in different projects either in the same Lab/Instt. or different Lab/Instt. of CSIR taken together shall not exceed 5 years in any case.
Hence, the applicants who have completed the total tenure of 5 years in any of the CSIR Lab/Instt. as Project Staff are NOT ELIGIBLE to apply for the aforesaid positions.
How to Apply –
Walk-in-Interview – Candidates fulfilling the above-mentioned qualification, age etc ., may attend the Walk-in-Interview scheduled as below
- For all the Posts – 19.05.2023 09.00 AM
at CSIR-Central Leather Research Institute, Sardar Patel Road, Adyar, Chennai – 600020 along with the application form and supporting documents.
The Application Form – is available on the CLRI website (https://clri.org/CareersForms.aspx). Candidates should attend the Walk-in-Interview with a duly filled in Application Form with self-attested photocopies of requisite certificates/ documents (viz . Date of Birth certificate, 10th or equivalent certificate, XII or equivalent certificate, Graduation certificate, experience proof (if applicable) etc.) along with original certificates for verification, a photo id proof like Aadhar Card, Voter I-Card or any other Photo ID Card issued by any Government Agency and 02 passport size colour photographs.
General Terms and Conditions –
- This is a purely temporary position
- The date of determining qualification and age shall be the date of Walk-in-Interview.
- Applications submitted other than in the enclosed prescribed Application form will not be considered.
- Candidates are requested NOT to send their applications by post speed post/ courier.
- The prescribed qualifications should have been obtained through recognized Universities/ Institutions etc.
- Incomplete application forms without requisite information, certificates/ documents, and photographs are liable -to be rejected.
- Any discrepancy found in the information given in the application that is evident in the original documents will make the candidate ineligible for appearing for the interview.
- If at any subsequent date it is detected/ found that the candidates have given incorrect
information or has withheld certain information or does not fulfil the eligibility criteria;
their candidature shall be cancelled without assigning any reason whatsoever. - The candidates attending the interview should bring along with them the duly signed application form, accompanied by self-attested photocopies of all the requisite certificates, mark sheets in support of age, educational qualifications, and experience (if applicable), and submit the same along with the original certificates, and mark sheets, at the time of attending an interview for verification.
- The candidates will not be allowed to attend the interview if they do not bring their application form and or requisite certificates/ mark sheets.
- Candidates would not be allowed beyond 11:00 a.m for those reporting time is 09:00 a.m on the date of the interview. Candidates would not be allowed beyond 03:00 p.m for those reporting time is 01:00 p.m on the date of the interview.
- No travelling allowance will be paid for attending Walk-in-Interview.
- Candidates attending interviews must follow COVID-related protocols/ SOPs.
- All applicants must fulfil the essential qualifications of the position and other conditions stipulated in the notification as of the date of the interview. They are advised to satisfy themselves before appearing for an interview and that they possess the essential qualifications laid down for the position they are applying. No enquiry asking for advice as to eligibility will be entertained.
- Document/ Certificate furnished in a language other than Hindi or English must be accompanied with an English transcript of the same duly attested by a Gazetted Officer or Notary.
- Canvassing in any form and/or bringing any political influence or otherwise will be treated as a disqualification for the position.
- The Director, CSIR-CLRI has a right to amend, delete and add terms & conditions to this notification.
Other Conditions
- Candidates found suitable for selection will be empanelled. Empanelled candidates may be selected for future project requirements.
- Final year/ Semester students, who are awaiting results are NOT ELIGIBLE to be considered.
- The Tenure mentioned above may be curtailed/ extendable. In any case, it is co-terminus with the project or till such time the requirement for the need of Project Assistant exists, whichever is earlier.
- In case of selection, Original certificates must be again produced for verification at the time of joining.
- The position is purely temporary and will not confer any right on the Project Assistant for permanent appointment in CLRI/ CSIR.
- The Director, CSIR-CLRI reserves the right to cancel the notification without assigning any reason thereof or reserves the right not to fill up the positions. The number of positions indicated against each position is provisional and may increase or decrease at the time of selection.
- The decision of the Director, CSIR-CLRI in all matters relating to eligibility, acceptance or rejection of applications will be final and binding on candidates.
Click here to download the application format
Check the notification below
Hey there, make sure you check out all of the possible interview questions for the various roles at CSIR -Central Leather Research Institute (CLRI) below.
- Question: Can you explain your experience in bulk production, factory plant erection, and commissioning? Have you worked on any projects involving DPR layout preparation in AutoCAD? Answer: In my previous role, I worked on a project that involved bulk production of [specific product] where I successfully managed the production process and ensured timely delivery. Additionally, I was part of a team responsible for factory plant erection and commissioning, where I collaborated with engineers and technicians to ensure smooth installation and operation. Regarding DPR layout preparation, I have experience using AutoCAD to design layouts for various projects, including [mention specific project].
- Question: How would your research or teaching/training experience benefit you in the role of a Project Associate-I? Answer: My research experience has equipped me with strong analytical skills and the ability to conduct thorough literature reviews and experiments. This would enable me to contribute effectively to the ongoing projects at CSIR-CLRI. Furthermore, my teaching and training experience has honed my communication and presentation skills, which would be valuable in disseminating project findings and collaborating with team members.
- Question: Can you discuss your area of expertise and publications in Biomaterials as a Senior Project Associate? Answer: As a Senior Project Associate, my expertise lies in the field of Biomaterials. I have worked extensively on developing novel biomaterials for biomedical applications, focusing on [mention specific applications or research areas]. My research contributions have been published in reputable scientific journals, including [mention specific publications]. These experiences have given me a deep understanding of biomaterials and their potential applications, which I believe would be highly relevant to the projects at CSIR-CLRI.
- Question: How do you ensure that your work aligns with the requirements and objectives of a specific project? Answer: To ensure alignment with project requirements and objectives, I make it a priority to thoroughly understand the project scope, objectives, and deliverables. I engage in regular communication with project stakeholders, including team members and project leaders, to clarify any uncertainties and obtain feedback. Additionally, I proactively monitor project progress and adjust my work accordingly to ensure that it aligns with the defined goals and meets the desired outcomes.
- Question: How do you stay updated with the latest developments in the field of Leather Science & Technology or your specific area of expertise? Answer: To stay updated with the latest developments, I actively participate in scientific conferences, workshops, and seminars related to Leather Science & Technology. I also subscribe to relevant scientific journals and publications to stay informed about the latest research findings and advancements. Furthermore, I engage in discussions with colleagues, collaborate with experts in the field, and leverage online platforms and forums to exchange knowledge and stay abreast of emerging trends and technologies.
Note: The answers provided here are general examples. It’s important to customize your responses based on your own experiences and expertise.
Editor’s Note: CLRI Project Openings 2023 For MSc, PhD Life Sciences – Attend Walk-In. CLRI Project Openings 2023. CLRI Project Openings 2023 Notification. Please make sure that you are subscribed to the Biotecnika Times Newsletter and our YouTube channel to be notified of all of the latest in the industry. Follow us on all of our social media like Twitter, Telegram, Facebook and Instagram.

Hello, sirand mam I am student of m.sc microbiology